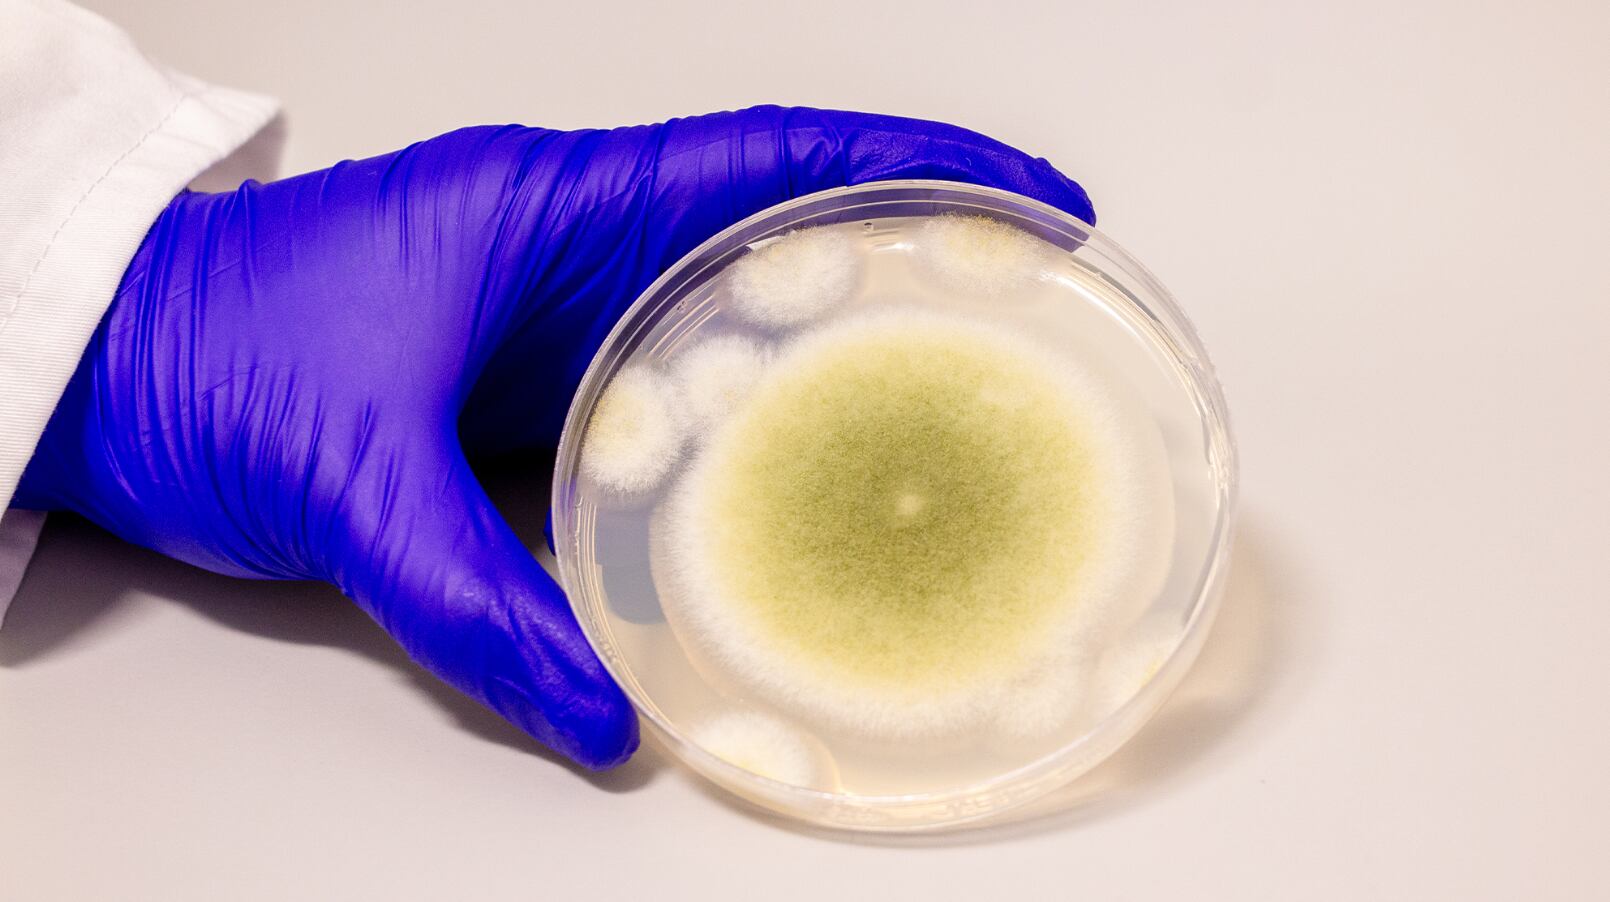
El estudio reveló que la adición de lípidos y el gen SLC46A3 potencian la acción de las asperigimicinas en células malignas (Universidad de Pensilvania/Bella Ciervo)

Un hongo históricamente vinculado con muertes misteriosas en excavaciones arqueológicas podría representar una nueva esperanza en el tratamiento de la leucemia. Investigadores de la Universidad de Pensilvania modificaron compuestos del Aspergillus flavus, conocido popularmente como el “hongo de la maldición del faraón”, para crear una sustancia capaz de eliminar células cancerosas.
Este hallazgo científico fue publicado en la revista Nature Chemical Biology, y difundido por Popular Science, donde se destacó el potencial de los hongos como fuente de medicamentos oncológicos.
El Aspergillus flavus es un hongo común en suelos y cultivos agrícolas, conocido por su toxicidad y su capacidad para infectar a personas con sistemas inmunológicos comprometidos. Su notoriedad trascendió la ciencia en la década de 1920, cuando varias muertes relacionadas con la apertura de la tumba de Tutankamón en Egipto alimentaron la leyenda de una “maldición del faraón”.
Según Popular Science, episodios similares se registraron en los años 70 tras la apertura de la tumba de Casimiro IV en Polonia, donde se detectó la presencia del hongo. Estos antecedentes contribuyeron a su reputación como organismo peligroso en contextos médicos y agrícolas.

El equipo de la Universidad de Pensilvania, liderado por la ingeniera química y biomolecular Sherry Gao y la investigadora Qiuyue Nie, se enfocó en una clase de compuestos conocidos como péptidos ribosomales sintetizados y modificados postraduccionalmente (RiPPs, por sus siglas en inglés). Aunque miles de RiPPs fueron identificados en bacterias, su presencia en hongos fue escasamente documentada.
Esto se debe a que los RiPPs fúngicos fueron durante años malinterpretados o confundidos con otros tipos de péptidos. El equipo analizó una docena de cepas de Aspergillus, comparando sus metabolitos con estructuras conocidas, y determinó que A. flavus era especialmente prometedor.
A través de estudios genéticos y metabólicos, los científicos localizaron una proteína clave involucrada en la producción de RiPPs. La desactivación de los genes que la codifican eliminó los compuestos asociados, lo que permitió confirmar su origen.
Tras purificar cuatro variantes, el equipo identificó una estructura común de anillos entrelazados, nunca antes descrita. Estas moléculas fueron nombradas como asperigimicinas. La científica Qiuyue Nie indicó que “la síntesis de estos compuestos es complicada, pero eso es lo que les da esta notable bioactividad”. Debido a esto, la dificultad en su purificación limitó su estudio.

Las asperigimicinas mostraron efectos significativos en cultivos de células humanas de leucemia. Dos de las variantes purificadas en la investigación, eliminaron eficazmente las células malignas.
Además, al añadir un lípido a otra de las variantes, su actividad fue comparable a la de citabarina y daunorubicina, medicamentos aprobados por la Administración de Alimentos y Medicamentos (FDA) para tratar la leucemia.
A su vez, las asperigimicinas no afectaron de forma relevante a células de cáncer de mama, hígado o pulmón, ni a otros microorganismos. Esta especificidad es clave en la búsqueda de tratamientos con menos efectos adversos.
La coautora del estudio, Sherry Gao, explicó que “estas sustancias bloquean la formación de microtúbulos, esenciales para la división celular”. Al impedir este proceso, se interrumpe el crecimiento descontrolado característico de las células cancerosas.
Más allá de las asperigimicinas, el estudio identificó secuencias genéticas similares en otros hongos, lo que sugiere la existencia de numerosos RiPPs fúngicos con potencial bioactivo. Nie subrayó que “aunque solo se encontraron unos pocos, casi todos tienen una fuerte bioactividad; esta es una región inexplorada con un potencial tremendo”.
El próximo paso para el equipo será probar las asperigimicinas en modelos animales, como preparación para futuros ensayos clínicos en humanos. Según difundió Popular Science, este proceso es indispensable para evaluar su seguridad y eficacia como tratamiento oncológico.
El equipo de la Universidad de Pensilvania destacó la importancia de seguir investigando los hongos como fuente de nuevas terapias. “Nos dieron la penicilina”, recordó Sherry Gao. Y agregó: “Estos resultados muestran que muchas más medicinas derivadas de productos naturales quedan por descubrir”.

Por su parte, Gao mencionó: “La naturaleza nos ha dado esta increíble farmacia. Es nuestro deber descubrir sus secretos. Como ingenieros, estamos entusiasmados por seguir explorando, aprendiendo de la naturaleza y usando ese conocimiento para diseñar mejores soluciones”.
El estudio difundido recientemente representa un avance significativo en la investigación de compuestos fúngicos con propiedades medicinales. Refuerza, además, la idea de que los productos naturales aún tienen un papel crucial en el desarrollo de tratamientos innovadores.
El 15 de enero de 2009, un Airbus A320 quedó sin motores tras despegar de Nueva York. La pericia de su tripulación permitió un amerizaje sin precedentes en el río Hudson
Infobae
Partidos de hoy jueves 15 de enero Las acciones continúan rumbo a las jornadas del fin de semana amartinezMié, 14/01/2026 - 23:56 Rumbo al tercer fin de semana del 2026, las acciones del deporte continúan dando de qué hablar, pues
Record
La decisión se publicó en Boletín Oficial y abarca geles y cremas base, neutros. Además, retiró del mercado lotes de una firma que trabajaba con Labortorios Solkotal
Infobae
Para quienes buscan decidir entre iPad y laptop para estudiar, trabajar o hacer tareas diarias, la mejor opción depende de lo que necesites: el iPad ofrece portabilidad y facilidad de uso, mientras que la laptop brinda potencia y compatibilidad con programas más completos.
Lado.mx
Consulta la agenda de encuentros programados para hoy. Los equipos mas destacados se enfrentaran en emocionantes duelos que prometen mantener a los aficionados al borde de sus asientos.
Lado.mx
Elegir una lavadora adecuada representa una inversión importante para cualquier hogar. Con tantas opciones disponibles, determinar cuál es la mejor marca de lavadoras puede resultar complicado si no conoces los criterios fundamentales que distinguen a un modelo de calidad de uno básico.
Lado.mx
STAFF/ @michangoonga/ RED 113 Le gustaba que le dijeran Francis “N” de cariño y, contó con amplio respaldo popular en el 2021 se convirtió en la primera mujer alcaldesa de Tanhuato abanderada por el PAN. Ahora ha sido detenida y vinculada a proceso señalada de corrupta. La Fiscalía Especializada de Combate a la Corrupción (FECC) …
Changoonga
De la redacciónEl Buen Tono La tarde de este miércoles 14 de enero, un tráiler cargado con productos lácteos quedó parcialmente incrustado bajo un puente peatonal sobre la avenida Lázaro Cárdenas, a la altura del cruce con la calle Veracruz, generando un caos vial en Xalapa. A pesar de la prohibición de paso, la pesada […]El cargo Tr
El buen tono
Consulta el horóscopo de hoy para el signo de Tauro. Conoce las predicciones astrológicas del 15 enero de 2026 en el trabajo, la salud y el amor para este signo del zodíaco
La Opinión de Los Ángeles
Están sentadas las bases para el retorno del "Cachorro" a campamento Franjeado.La entrada Caso Richard Sánchez: el dineral que espera Racing de Olimpia aparece primero en Versus.
Versus.com.py
ESPN Deportes
Apple lanza Creator Studio: precios, apps incluidas y funciones de IA Una plataforma para diseñadores, estudiantes, músicos y gente que hace contenido digital jreyesMié, 14/01/2026 - 11:24 Apple presentó oficialmente su nuevo servi
Record
FOTO/AMEXI/ IG Bogotá, 11 enero (Amexi/Notistarz).- El cantante colombiano Yeison Jiménez, predijo su propia muerte semanas atrás, misma que soñó en tres ocasiones y que al final le quitó la… La entrada Esta fue la predicción de Yeison Jiménez sobre su muerte que terminó por cumplirse se publicó primero en Notistarz.
Notistarz
La muerte del cantante colombiano, Yeison Jiménez, ha conmocionado a propios y ajenos, ya que trágicamente perdió la vida en un accidente aéreo junto a miembros de su equipo de trabajo. El lamentable hecho tuvo lugar la tarde del sábado, cuando Yeison viajaba en una avioneta privada, desde el aeropuerto de Paipa hacia Medellín, en Colomb
El Siglo de Torreón
Redacción / Grupo Cantón Con 34 años, el cantante colombiano de música popular era reconocido por su potente voz y su carisma en el escenario, dejando un legado que marcó a toda una generación. Colombia.- Yeison Andrés Jiménez Valencia nació en Aguazul, Casanare, Colombia, y desde joven mostró pasión por la música popular. Se convirtió
Quintana Roo Hoy
Oppo acaba de lanzar en Taiwán sus dos nuevos integrantes de la familia Reno 15: el Reno 15 Pro y Reno 15 Pro Max. La gran apuesta está en el modelo más ambicioso, el Pro Max, que llega con un sistema de cámaras de 200 megapíxeles, un procesador Dimensity 8450 y una batería que p
Xataka México
La nueva Siri más inteligente de Apple será potenciada por Google Gemini. Apple ha elegido a la inteligencia artificial de Google para dar vida a su renovada asistente virtual, reporta CNBC. La nueva versión de Siri, la mayor actualización de su historia, llegará más adelante est
Xataka México
Hace unos años, Apple reveló una de las jugadas más ambiciosas del sector: ChatGPT sería la base del futuro de Siri. Con aquel acuerdo, la firma norteamericana confió en que los modelos de inteligencia artificial de OpenAI fueran capaces de darles un salto de calidad necesario en
3d Juegos
Charros de Jalisco, Tomateros de Culiacán, Águilas de Mexicali y Algodoneros de Guasave buscarán su boleto a la gran final
Infobae
Pitcheo efectivo y bateo oportuno colocan a Culiacán arriba en la serie antes de viajar a Guasave.
El Imparcial
Con dos equipos que tienen franca ventaja, esta noche se reanudarán las acciones dentro de las series semifinales en la Liga Mexicana del Pacífico, que esta misma semana busca tener definidos a sus equipos finalistas.¿OTRO NUEVO CLÁSICO? Los Tomateros de Culiacán tienen ventaja de 2 juegos por 0 sobre los Algodoneros de Guasave, mientras q
El Siglo de Torreón
Últimas noticias
Xalapeña asume como alcaldesa de Nueva Orleans
Colapsa sistema de agua potable; deja sin servicios a usuarios de Amatlán
Alfredo Adame asegura que Enrique Alonso "Cachirulo" intentó abusar de él
VIDEO Pasajeros graban desde el vagón momento del descarrilamiento
Frente frío 25 provocará caída de nieve en algunas zonas de México
Sismo de 4.1 se registra al noroeste de Sonora
Fiebre de fin de año dispara ventas en carnicerías del Mercado Municipal
Frente Estatal de Autos respalda cancelación de regularización de vehículos extranjeros
Se apoyó a 96 adultos mayores en Casa de los Abuelos durante 2025
Fast Track impulsa el emprendimiento local en Hermosillo
¡Freno a la pirotecnia! Aseguran más de 777 kilos en Hermosillo
Modernizan flota de transporte en Hermosillo
Arranca nueva etapa en Isssteson con relevo en la dirección
Reanuda Gobierno de Ensenada servicio de pasaportes
Logra Punto Verde más de 100 mil kilos recolectados: Claudia Agatón